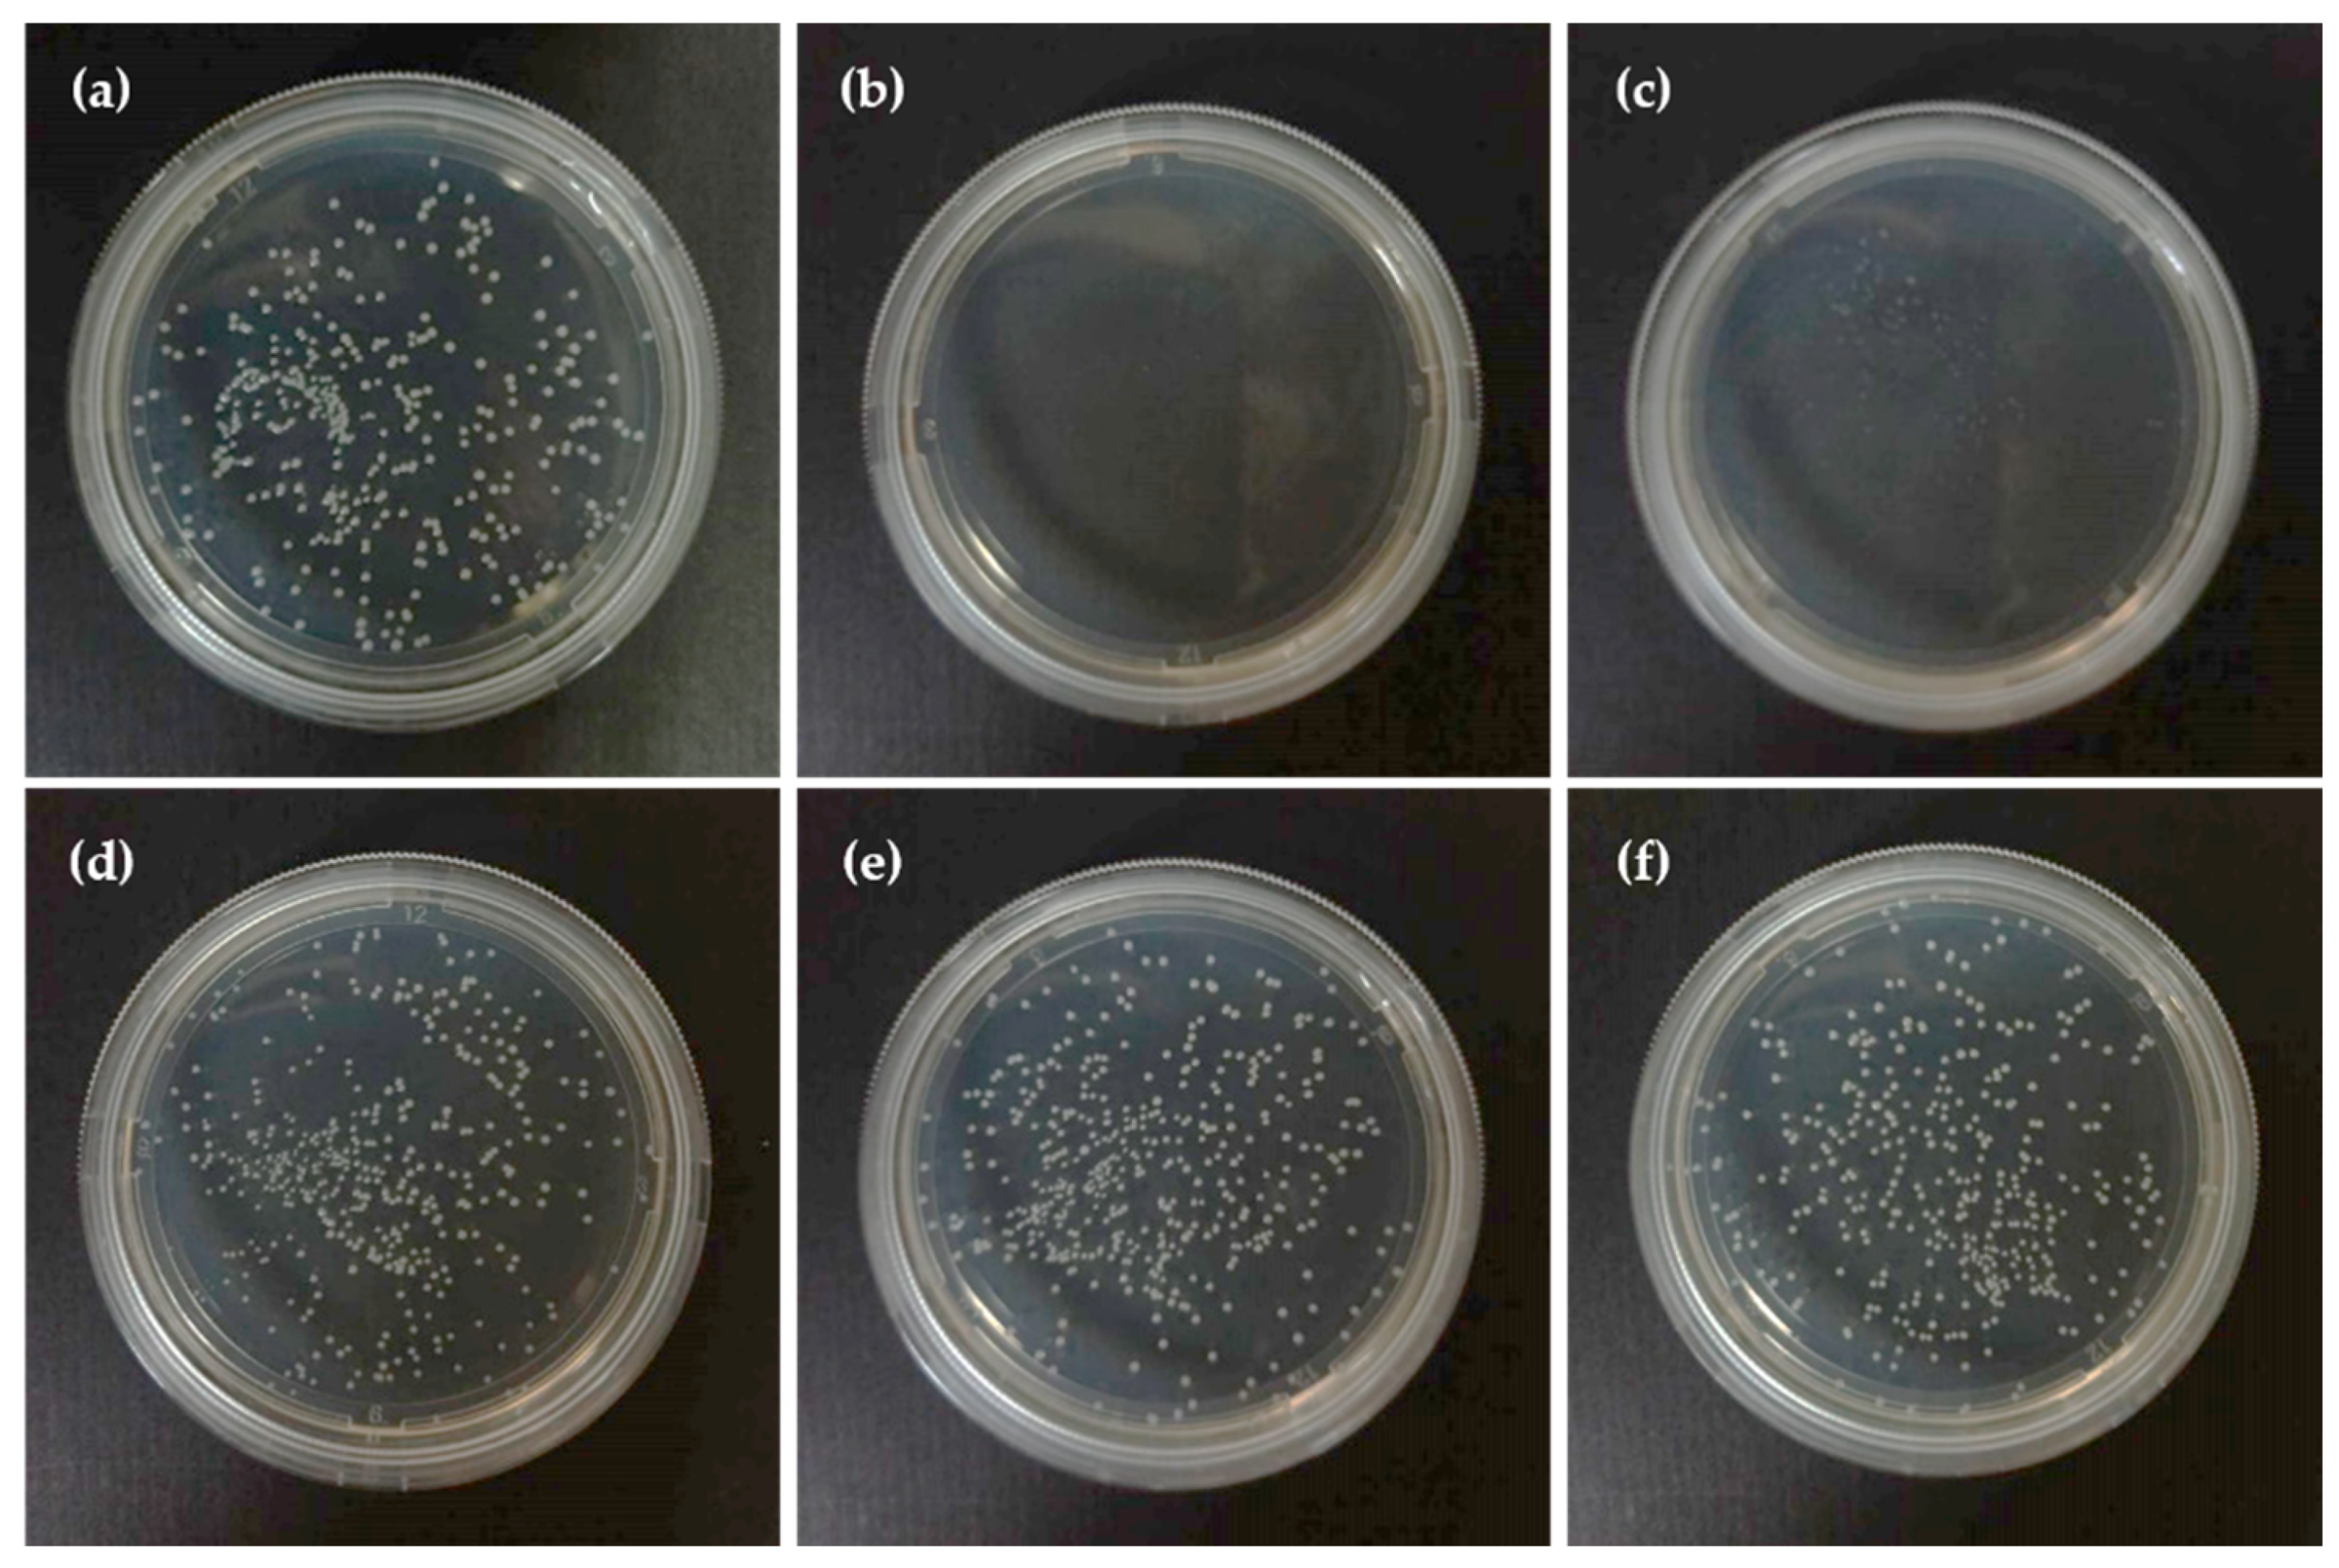

Novel Epigallocatechin-3-Gallate (EGCG)-Loaded Mesoporous Bioglass Scaffolds for Bone Recruitment Applications
Abstract
1. Introduction
2. Materials and Methods
2.1. MBG Scaffold
2.2. Characterization
2.3. Antibacterial Activity of EGCG
2.4. EGCG-MBG Scaffold
2.5. Release of EGCG
2.6. Cell Live Assay
2.7. Statistical Analysis
3. Results and Discussion
3.1. Characterization of the MBG Scaffold
3.2. Antibacterial Assessment of EGCG
3.3. The Bioactivity of the EGCG-MBG Scaffold
3.4. Drug Release of EGCG-MBG
3.5. Cytocompatibility of Scaffolds
4. Conclusions
Author Contributions
Funding
Data Availability Statement
Conflicts of Interest
References
- Zhu, Q.; Ablikim, Z.; Chen, T.; Cai, Q.; Xia, J.; Jiang, D.; Wang, S. The preparation and characterization of HA/ß-TCP biphasic ceramics from fish bones. Ceram. Int. 2017, 43, 12213–12220. [Google Scholar] [CrossRef]
- Ma, J.; Huang, B.X.; Zhao, X.C.; Wang, C.Z.; Zhang, H.M. Effect of zinc substitution for calcium on the structure, dissolution behavior and apatite formation of CaO-ZnO-SiO2-P2O5 bioceramics. Mater. Lett. 2017, 206, 154–157. [Google Scholar] [CrossRef]
- Xu, Y.; Gao, D.; Feng, P.; Gao, C.; Pengcd, S.; Ma, H.; Yang, S.; Shuai, C. A mesoporous silica composite scaffold: Cell behaviors, biomineralization and mechanical properties. Appl. Surf. Sci. 2017, 423, 314–321. [Google Scholar] [CrossRef]
- Wu, F.; Liu, C.; O’Neill, B.; Wei, J.; Ngothai, Y. Fabrication and properties of porous scaffold of magnesium phosphate/polycaprolactone biocomposite for bone tissue engineering. Appl. Surf. Sci. 2012, 258, 7589–7595. [Google Scholar] [CrossRef]
- Wers, E.; Oudadesse, H.; Lefeuvre, B.; Merdrignac-Conanec, O.; Barroug, A. Evalution of the kinetic and relaxation time of gentamicin sulfate released from hybrid biomaterial bioglass-chitosan scaffolds. Appl. Surf. Sci. 2015, 353, 200–208. [Google Scholar] [CrossRef]
- Wang, Q.; Tang, P.; Ge, X.; Li, P.; Lv, C.; Wang, M.; Wang, K.; Fang, L.; Lu, X. Experimental and simulation studies of strontium/zinc-codoped hydroxyapatite porous scaffolds with excellent osteoinductivity and antibacterial activity. Appl. Surf. Sci. 2018, 462, 118–126. [Google Scholar] [CrossRef]
- Řehořek, L.; Chlup, Z.; Meng, D.; Yunos, D.; Boccaccini, A.; Dlouhy, I. Response of 45S5 Bioglass® foams to tensile loading. Ceram. Int. 2013, 39, 8015–8020. [Google Scholar] [CrossRef]
- Chen, X.; Li, S.; Yan, Y.; Su, J.; Wang, D.; Zhao, J.; Wang, S.; Zhang, X. Absorbable nanocomposites composed of mesoporous bioglass nanoparticles and polyelectrolyte complexes for surgical hemorrhage control. Mater. Sci. Eng. C 2020, 109, 110556. [Google Scholar] [CrossRef]
- Shoaib, M.; Saeed, A.; Rahman, M.S.U.; Naseer, M.M. Mesoporous nano-bioglass designed for the release of imatinib and in vitro inhibitory effects on cancer cells. Mater. Sci. Eng. C 2017, 77, 725–730. [Google Scholar] [CrossRef]
- Calabrese, G.; Petralia, S.; Franco, D.; Nocito, G.; Fabbi, C.; Forte, L.; Guglielmino, S.; Squarzoni, S.; Traina, F.; Conoci, S. A new Ag-nanostructured hydroxyapatite porous scaffold: Antibacterial effect and cytotoxicity study. Mater. Sci. Eng. C 2021, 118, 111394. [Google Scholar] [CrossRef]
- Zhang, J.; Zhu, S.; Song, K.; Wang, Z.; Han, Z.; Zhao, K.; Fan, Z.; Zhou, X.; Zhang, Q. 3D reduced graphene oxide hybrid nano-copper scaffolds with a high antibacterial performance. Mater. Lett. 2020, 267, 127527. [Google Scholar] [CrossRef]
- Ballarre, J.; Aydemir, T.; Liverani, L.; Roether, J.; Goldmann, W.; Boccaccini, A.R. Versatile bioactive and antibacterial coating system based on silica, gentamicin, and chitosan: Improving early stage performance of titanium implants. Surf. Coat. Technol. 2020, 381, 125138. [Google Scholar] [CrossRef]
- Rajabi, A.; Esmaeili, A. Preparation of three-phase nanocomposite antimicrobial scaffold BCP/Gelatin/45S5 glass with drug vancomycin and BMP-2 loading for bone regeneration. Colloids Surf. A Physicochem. Eng. Asp. 2020, 606, 125508. [Google Scholar] [CrossRef]
- El-Sayed, S.A.; Mabrouk, M.; Khallaf, M.E.; El-Hady, B.M.A.; El-Meliegy, E.; Shehata, M.R. Antibacterial, drug delivery, and osteoinduction abilities of bioglass/chitosan scaffolds for dental applications. J. Drug Deliv. Sci. Technol. 2020, 57, 101757. [Google Scholar] [CrossRef]
- Cabrera-Vique, C.; Artacho, R.; Giménez, R. Beneficial Effects of Green Tea—A Review. J. Am. Coll. Nutr. 2006, 25, 79–99. [Google Scholar] [CrossRef] [PubMed]
- Forouzideh, N.; Nadri, S.; Fattahi, A.; Abdolahinia, E.D.; Habibizadeh, M.; Rostamizadeh, K.; Baradaran-Rafii, A.; Bakhshandeh, H. Epigallocatechin gallate loaded electrospun silkfibroin scaffold with anti-angiogenic properties for corneal tissue engineering. J. Drug Deliv. Sci. Technol. 2020, 56, 101498. [Google Scholar] [CrossRef]
- Kühne, B.A.; Puig, T.; Ruiz-Martínez, S.; Crous-Masó, J.; Planas, M.; Feliu, L.; Cano, A.; García, M.L.; Fritsche, E.; Llobet, J.M.; et al. Comparison of migration disturbance potency of epigallocatechin gallate (EGCG) synthetic analogs and EGCG PEGylated PLGA nanoparticles in rat neurospheres. Food Chem. Toxicol. 2019, 123, 195–204. [Google Scholar] [CrossRef]
- Chu, C.; Wang, Y.; Wang, Y.; Yang, R.; Liu, L.; Rung, S.; Xiang, L.; Wu, Y.; Du, S.; Man, Y.; et al. Evaluation of epigallocatechin-3-gallate (EGCG) modified collagen in guided bone regeneration (GBR) surgery and modulation of macrophage phenotype. Mater. Sci. Eng. C 2019, 99, 73–82. [Google Scholar] [CrossRef]
- Chen, C.-H.; Ho, M.-L.; Chang, J.-K.; Hung, S.-H.; Wang, G.-J. Green tea catechin enhances osteogenesis in a bone marrow mesenchymal stem cell line. Osteoporos. Int. 2005, 16, 2039–2045. [Google Scholar] [CrossRef]
- Chen, C.-H.; Kang, L.; Lin, R.-W.; Fu, Y.-C.; Lin, Y.-S.; Chang, J.-K.; Chen, H.-T.; Chen, C.-H.; Lin, S.-Y.; Wang, G.-J.; et al. (−)-Epigallocatechin-3-gallate improves bone microarchitecture in ovariectomized rats. Menopause 2013, 20, 687–694. [Google Scholar] [CrossRef]
- Lin, S.-Y.; Kang, L.; Chen, J.-C.; Wang, C.-Z.; Huang, H.H.; Lee, M.-J.; Cheng, T.-L.; Chang, C.-F.; Lin, Y.-S.; Chen, C.-H. (−)-Epigallocatechin-3-gallate (EGCG) enhances healing of femoral bone defect. Phytomedicine 2019, 55, 165–171. [Google Scholar] [CrossRef] [PubMed]
- Mah, Y.-J.; Song, J.S.; Kim, S.-O.; Lee, J.-H.; Jeon, M.; Jung, U.-W.; Moon, S.J.; Kim, J.-H.; Choi, H.-J. The effect of epigallocatechin-3-gallate (EGCG) on human alveolar bone cells both in vitro and in vivo. Arch. Oral Biol. 2014, 59, 539–549. [Google Scholar] [CrossRef] [PubMed]
- Kokubo, T.; Takadama, H. How useful is SBF in predicting in vivo bone bioactivity? Biomaterials 2006, 27, 2907–2915. [Google Scholar] [CrossRef] [PubMed]
- Rainer, A.; Giannitelli, S.M.; Abbruzzese, F.; Traversa, E.; Licoccia, S.; Trombetta, M. Fabrication of bioactive glass–ceramic foams mimicking human bone portions for regenerative medicine. Acta Biomater. 2008, 4, 362–369. [Google Scholar] [CrossRef] [PubMed]
- Baino, F.; Fiorilli, S.; Vitale-Brovarone, C. Bioactive glass-based materials with hierarchical porosity for medical applications: Review of recent advances. Acta Biomater. 2016, 42, 18–32. [Google Scholar] [CrossRef] [PubMed]
- Yoda, Y.; Hu, Z.-Q.; Shimamura, T.; Zhao, W.-H. Different susceptibilities of Staphylococcus and Gram-negative rods to epigallocatechin gallate. J. Infect. Chemother. 2004, 10, 55–58. [Google Scholar] [CrossRef]
- Chu, C.; Deng, J.; Hou, Y.; Xiang, L.; Wu, Y.; Qu, Y.; Man, Y. Application of PEG and EGCG modified collagen-base membrane to promote osteoblasts proliferation. Mater. Sci. Eng. C 2017, 76, 31–36. [Google Scholar] [CrossRef]

Publisher’s Note: MDPI stays neutral with regard to jurisdictional claims in published maps and institutional affiliations. |
© 2020 by the authors. Licensee MDPI, Basel, Switzerland. This article is an open access article distributed under the terms and conditions of the Creative Commons Attribution (CC BY) license (http://creativecommons.org/licenses/by/4.0/).
Share and Cite
Ou, S.-F.; Tsao, Y.-L.; Lin, W.-C.; Wang, Y.-T.; Wang, L.; Fan, F.-Y. Novel Epigallocatechin-3-Gallate (EGCG)-Loaded Mesoporous Bioglass Scaffolds for Bone Recruitment Applications. Appl. Sci. 2021, 11, 243. https://doi.org/10.3390/app11010243
Ou S-F, Tsao Y-L, Lin W-C, Wang Y-T, Wang L, Fan F-Y. Novel Epigallocatechin-3-Gallate (EGCG)-Loaded Mesoporous Bioglass Scaffolds for Bone Recruitment Applications. Applied Sciences. 2021; 11(1):243. https://doi.org/10.3390/app11010243
Chicago/Turabian StyleOu, Shih-Fu, Yuan-Li Tsao, Wei-Chun Lin, Yi-Ting Wang, Liping Wang, and Fang-Yu Fan. 2021. "Novel Epigallocatechin-3-Gallate (EGCG)-Loaded Mesoporous Bioglass Scaffolds for Bone Recruitment Applications" Applied Sciences 11, no. 1: 243. https://doi.org/10.3390/app11010243
APA StyleOu, S.-F., Tsao, Y.-L., Lin, W.-C., Wang, Y.-T., Wang, L., & Fan, F.-Y. (2021). Novel Epigallocatechin-3-Gallate (EGCG)-Loaded Mesoporous Bioglass Scaffolds for Bone Recruitment Applications. Applied Sciences, 11(1), 243. https://doi.org/10.3390/app11010243

